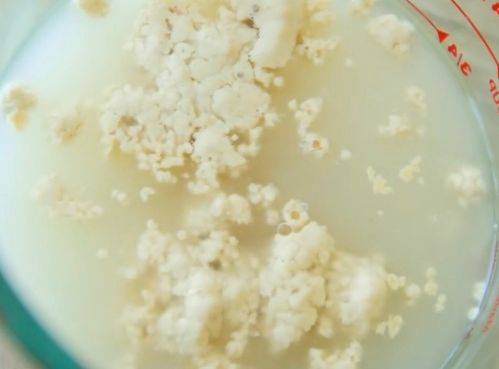

Секрет 5. Особый подход
К некоторым плодам нужен особый подход
- Ягоды черноплодной рябины перед варкой необходимо 1-2 минуты бланшировать в кипятке — так они останутся сочными. При приготовлении варенья из черноплодной рябины в него необходимо добавлять лимонную кислоту.
- Чтобы при варке варенья ягоды черной смородины не стали сухими, их нужно бланшировать 1 мин. в кипятке.
- Чтобы во время кипячения абрикосы и сливы не разварились, непосредственно перед варкой замочите их на 5 минут в растворе соды. Для приготовления раствора в 1,5 л воды растворите 1 ч. ложку соды.
- Чтобы в процессе варки варенья яблоки не потемнели, на 2-3 минуты опустите нарезанные дольки в соленую воду (на 0,5 л воды возьмите 1 ч. ложку соли), а затем на такое же время погрузите в кипяток.
- Чтобы ягоды и фрукты с твердой кожицей (сливы, крыжовник, груши и другие) сохранили свою форму, а кожура их не лопнула, перед варкой проколите ее в нескольких местах зубочисткой.
Яблочный джем — рецепт приготовления
Варить яблочный джем можно, что называется на глазок. Ведь итоговая консистенция полностью зависит от использованных яблок и желаемого результата. Чтобы сделать вкус джема более пикантным, по желанию можно добавить немного лимона, апельсина, корицы или ванилина.
- Яблоки очищенные – 1 кг;
- Сахар – 0.75 г;
- Вода кипяченая – ½ ст.
Приготовление:
- Яблоки помойте, очистите от семенной коробочки и кожуры. Натрите на крупненькой терке.
- Из указанного количества сахара и воды сварите сироп и влейте его в натертые фрукты.
- Поставьте на огонь и после закипания массы варите около часа, уменьшив огонь до минимального.
- Во время уваривания не забывайте время от времени мешать яблочное пюре.
- Как только яблочная стружка хорошо проварится, а джем приобретет задуманную консистенцию, охладите естественным образом.
- Разложите в баночки и храните под пластиковыми крышками в холодильнике или под металлическими в погребе.
Одуванчиковое варенье с вишневыми листьями
Что нужно (на 0,5 л):
- лепестки одуванчиков – 100 шт.;
- сахар – 0,3-0,35 кг;
- лимон – 0,5 шт.;
- вода – 0,4 л;
- листья вишни – 2-3 шт.
Как приготовить:
- Листья вишни и цветки одуванчиков хорошо промойте в проточной воде.
- Лимон обдайте кипятком, помойте, затем нарежьте вместе с кожурой небольшими кусочками.
- Подготовленные на предыдущих этапах ингредиенты сложите в кастрюлю или варочный таз, залейте водой. Подогрейте.
- Поварите лимоны, одуванчики и листья 10 минут после того, как жидкость закипит.
- Настоите в течение суток в прохладном месте, затем процедите через сложенную в несколько слоев марлю.
- В полученную ароматную жидкость всыпьте сахар. Варите смесь до желаемой густоты от 30 до 60 минут.
- Разлейте ароматный сироп по баночкам, которые нужно перед этим простерилизовать.
Остается плотно закрыть емкости, остудить до комнатной температуры и убрать на зиму в кладовку или другое место, отведенное в вашем доме для этой цели.

Заливной грушевый пирог на кефире в духовке
Просто вкусный мягкий и сочный пирог на кефире с сезонными грушами. Многие этот фрукт в свежем виде не едят, а вот в выпечке похоже все любят. Груши желательно взять сладкие и сочные, спелые.
Ингредиенты на форму 18-20 см
- Груши — 3 большие и спелые
- Яйца — 2 шт
- Сахар — 150 гр
- Масло оливковое (подсолнечное) — 60 мл
- Кефир — 90 мл
- Мука белая — 160 гр
- Разрыхлитель — 1 пакетик
- Сок 1 лимона
- Пудра сахарная для обсыпки
Вымоем груши и дадим стечь воде. Очищаем 2 штуки и нарезаем небольшими кусочками. Сбрызгиваем лимонным соком, во избежание потемнения.
Выбьем яйца и насыпем сахар в чашу планетарного миксера, взобьем пару минут до белой пены и увеличения объема. Медленно введем растительное масло, затем кефир. Всыпем просеянную муку и разрыхлитель.
Засыплем в смесь нарезанную грушу и перемешаем. Заливаем тесто в форму, застеленную пергаментной бумагой.
Третью грушу разрезаем на 4 части, удаляем сердцевину и нарезаем дольками. Поливаем лимонным соком. Выкладываем на пирог нарезанные груши и посыпаем сверху сахаром.
Выпекаем в горячей духовке при температуре 180 примерно 30-40 минут. Грушевый пирог на кефире готов, если деревянная шпажка, засунутая в центр выходит сухой. Достаем из духовки и даем остыть на решетке.
Ваш заливной пирог с грушами готов для домашнего чаепития в кругу родных и близких! Грушевый пирог на кефире даже на третий день остается мягким и влажным… И он действительно очень вкусен!
Венский пирог с замороженной вишней и миндалем
Венский пирог считается одним из самых вкусных. Хотя приготовить его совсем несложно. В основе идет масляный бисквит, который ароматизируется экстрактом ванили. Также по классике нужно использовать миндальные лепестки, которые придадут особый вкус.
Ингредиенты:
- замороженная вишня — 400 гр.
- пшеничная мука — 200 гр.
- сливочное масло комнатной температуры — 180 гр.
- сахар — 140 гр.
- яйца — 4 шт.
- разрыхлитель — 1 ч.л
- экстракт ванили — 1 ч.л.
- лепестки миндаля — 2 ст.л.
Приготовление:
1.В чашу миксера положите размягченное сливочное масло, к нему всыпьте сахар и взбейте в течении 4 минут на средней скорости, чтобы получилась пышная масса.
2.Добавьте одно яйцо, вмешайте его, потом добавьте по одному остальные яйца. Все вместе взбейте.

3.Всыпьте 100 гр. просеянной муки с разрыхлителем, налейте экстракт ванили, перемешайте. И, наконец-то, добавьте оставшуюся муку и взбивайте тесто еще 3 минуты. На самом деле, все готовится просто. Но продукты добавляются не все сразу, а частями. Получается нежная масса, гладкая, не текучая и пышная.
4.Возьмите большую форму для выпечки — 26 см — смажьте ее сливочным маслом и присыпьте мукой. Получится «французская рубашка». Высыпьте в подготовленную емкость тесто и лопаткой разровняйте.

5.Вишня должна быть разморожена, а сок слит. Ягоды не должны быть слишком мокрыми. Выложите их сверху на пирог.
6.И финальный штрих — миндальные лепестки на вишню. Выпекайте 30-35 минут при температуре 180 градусов.

7.Как обычно, нужно дождаться остывания и затем разрезать. Это очень вкусно, можно язык проглотить, хотя и достаточно калорийно. По традиции можно присыпать сахарной пудрой для декора.

Рецепт 8: творожный пирог с вареньем в духовке (пошагово с фото)
- мука — 3 стакана
- масло сливочное — 180 гр
- яйцо куриное — 2 шт
- сахар — 4 ст.л.
- творог — 400 гр
- сода — 0,5 ч.л.
- крахмал — 2 ст.л.
- варенье — 250 гр
Разотрите творог (200 г.) с сахаром (2 ст.л.) и 1 яйцом.
Если творог останется крупинками, даже лучше.
Масло растопить, добавить к творожной массе. Добавьте соду.
Всыпьте муку и замесите тесто.
Тесто отправить на полчаса в холодильник. Накройте его плёнкой.
Через полчаса разделите тесто на две части – большую и маленькую. Большой кусок раскатайте и выложите в форму.
Из меньшего куска теста сформируйте бортик для будущего пирога.
Разотрите 200 г. творога с одним яйцом, 1 ст.л. крахмала и 2 ст.л. сахара.
Выложить творожную массу на корж, присыпанный крахмалом.
Варенье размешать с 1 ст.л. крахмала.
Выложить его на творожную массу.
Выпекать пирог в духовке при температуре 180 градусов 40-45 минут.
Коврижка в мультиварке с вареньем
Ну и заключительный вариант, это пирог который готовится в мультиварке. На его приготовление уйдет тоже достаточно мало времени, а итог всегда порадует. Ведь чудопечь этим и хороша, закинул все продукты, а уже после наслаждаешься готовым изделием. Главное все сделать правильно.

Нам понадобится:
- Варенье — 1ст.
- Кефир — 1ст.
- Сахар — 0,5 ст.
- Яйца куриные — 2шт.
- Сода пищевая — 2 ч.л
- Соль — щепотка
- Мука пшеничная — 2 ст.
Источник https://www.youtube.com/watch?v=9IKF2sScsJI
Этапы:
Шаг 1.
В миску вылейте варенье и добавьте соды. Перемешайте, чтобы сода перегасилась. Увидите шипение и необычную реакцию.

Шаг 2.
После добавьте пару яиц и размешайте столовой ложкой. Плюс внесите щепотку соли и сахарный песок с кефиром. Размешайте, получится воздушная текстура теста.
Теперь частями добавляйте муку, чтобы не переборщить. Должна получиться консистенция густой сметаны.

Шаг 3.
Форму мультиварки смажьте сливочным маслом и вылейте тесто. Выставите пирог в мультиварку и закройте крышку. Выберите режим Выпечка и время 1 час 20 минут.

Шаг 4.
По истечению времени проверьте деревянной палочкой готовность. Если она становится мокрой, то добавьте еще 15 минут на выпекание, если сухая, то коврижка готова.

Шаг 5.
Доставайте пирог из чаши мультиварки при помощи пароварки. Украшайте по желанию. Кушайте на здоровье с чаем или молоком. Приятного аппетита!

На этом все, надеюсь ваша коврижка с вареньем получилась великолепная на вкус и красивая снаружи. Выпекайте такие пироги не только в будние дни, но и можно сделать такую выпечку на праздник. Просто верх украсьте кремом или глазурью, а сам тортик пропитайте сметаной. Получится ну очень вкусно и необычно.
Ну, а теперь как и обещала мое видео:
Всем до скорого и до новых встреч. До свидания, пишите комментарии внизу статьи, если что-то непонятно. Обязательно отвечу.
Как приготовить тертый пирог с вишней
Тертый пирог с вишней – настоящий летний десерт. Мягкая и нежная сладко-кислая вишня сделает обычный пирог роскошным лакомством. Для приготовления может использоваться свежая ягода или замороженная вишня.
Продукты:
- 100 гр. маргарина или сливочного масла;
- 2-3 яйца;
- 200 гр. сахарного песка для приготовления теста;
- 100 гр. сахарного песка для приготовления вишневой начинки;
- 2 стакана муки;
- 400 гр. свежей или размороженной вишни;
- 1 пакетик ванильного сахара.
Приготовление:
- Для приготовления теста яйца и сахар взбивают блендером до появления белой пены и полного растворения крупинок сахарного песка.
- В полученную смесь вливают растопленное до 40 градусов масло или маргарин.
- Смесь взбивают и постепенно добавляют всю муку из этого рецепта. В конце добавляют разрыхлитель и ванильный сахар.
- Готовое тесто делят на две равные части и убирают в морозильную камеру. Через час оно полностью замерзает.
- Твердое тесто трут на крупной терке, создавая первый слой теста. На него выкладывают смешанную с сахаром вишню. В очень сочную вишню при приготовлении начинки можно добавить 1-2 чайные ложки крахмала, который свяжет сок ягод и не даст ему вытечь при приготовлении. Начинку закрывают еще одним слоем натертого на крупной терке замороженного теста.
- Заготовку отправляют в горячую духовку на 30 минут. Поверхность готового пирога посыпают сахарной пудрой.
- Выпекать тертый постный пирог нужно в разогретой до 200 градусов духовке примерно 20 минут. Готовое изделие можно посыпать сахарной пудрой, сладкой присыпкой или орешками.

Мягкие и пышные маковые булочки на кефире
Цветки мака поражают своей простотой, а также ярким сочетанием красного и черного цвета. Мне очень хотелось и булочки сделать такими же красивыми. Перебрав массу вариантов красивого оформления дрожжевого теста с начинкой, домочадцы одобрили соединенные в кольца перекрученные черно-белые полосочки. В готовом виде форма такой пышной выпечки действительно выглядит, как нежные лепестки.
Сдобу лучше всего завести на не слишком жирном кефире или йогурте – так корочка получится более хрустящей, хотя внутри сохранится нежный мякиш. А для придания яркости перед выпечкой заготовки желательно смазать растопленным сливочным маслом или же яично-молочной смесью.
Ингредиенты:
- Мука – 350 гр. + для подсыпки.
- Сахарный песок – 100 гр. + 60 гр.
- Кулинарный мак – 100 гр.
- Сливочное масло – 80 гр. + 1,5 ст. л.
- Сухие дрожжи – 7 гр.
- Кефир, вода – по 200 мл.
- Яйцо – 1 шт.
- Подсолнечное масло – 1 ст. л.
- Соль – 1 щепотка.
Приготовление:
Подогреваем кефир любым удобным способом до 35 градусов. Затем всыпаем в него сухие гранулированные дрожжи и пару ложек сахарного песка. Хорошенько растворяем сыпучие продукты в кисломолочной жидкости и оставляем в покое на четверть часа, чтобы смесь начала покрываться пенной шапочкой – так мы получим кефирную опару.
Растапливаем сливочное масло и, охладив его до 22-25 градусов, вливаем к предыдущим ингредиентам. Туда же вбиваем свежее яйцо и подсыпаем сахар (≈ 80 гр.) со щепоткой соли. При помощи венчика соединяем до однородной массы.
Просеиваем муку и в три приема вводим ее в кефирную основу, постоянно перемешивая ложкой, а затем рукой. Тесто получится слегка липкое, но это не страшно. Прикрываем емкость с замесом чистой хлопковой тканью или затягиваем пищевой пленкой. Оставляем в покое минимум на полчаса, чтобы содержимое чаши увеличилось хотя бы в два раза.
Перекладываем тесто на припыленный мукой стол и начинаем его выминать до тех пор, пока оно не превратится в нетугой, но довольно упругий мягкий шар (≈5-8 минут). Затем снова отправляем в чашку и даем полчаса, чтобы масса смогла подняться еще раз.
Не теряя времени, заливаем кулинарный мак кипящей водой и варим 5 минут. Затем отключаем нагрев плиты и даем семечкам размокнуть еще в течение четверти часа. Сливаем жидкость, а зернышки смешиваем с сахарным песком (60 гр.) и перемалываем ручным блендером.
Готовое тесто снова слегка обминаем и придаем ему форму кирпичика. Выкладываем его на слегка посыпанную мукой рабочую поверхность стола и скалкой превращаем его в широкий прямоугольник. Сильно тонким его делать не стоит, чтобы потом заготовки не разрывались. Лучше всего раскатать его до пол сантиметровой толщины.
Выкладываем сахарно-маковую массу на подготовленное тесто и ложкой размазываем по поверхности, стараясь распределить ровным слоем, не захватывая края.
Осторожно приподняв с одной стороны пласт, складываем его пополам так, чтобы внутри оказался двойной слой начинки. Обязательно прищипываем краешки, противоположные сгибу, чтобы потом было удобнее проводить формирование булочек
Разрезаем получившуюся конструкцию пиццерезом или очень острым ножом на одинаковые ленты шириной в 3,5 сантиметра.
Взяв каждую полосочку за кончики, проворачиваем ее по часовой стрелке 4-6 раз, чтобы получился своеобразный «канатик». Сворачиваем его в колечко и хорошенько скрепляем между собой начало с концом этой скрутки.
Смазываем противень подсолнечным маслицем. Сразу же на отдалении друг от друга раскладываем заготовки и даем им расстояться треть часа. Чтобы они не подсохли, желательно на это время прикрыть их чистым вафельным полотенцем.
Растапливаем полторы ложки сливочного масла и промазываем им увеличившиеся в объеме булочки. Но делать это надо так, чтобы кисточка прошлась только по тесту и не затронула маковые полосочки, иначе они быстро подсохнут в печи.
Отправляем сдобу на полчаса запекаться в духовке при 180 градусах. Готовое лакомство выставляем на стол, слегка сбрызгиваем водой и прикрываем полотенчиком. Эта манипуляция позволит сделать горячую похрустывающую поверхность пышных булочек более мягкой. Через четверть часа выпечку можно переложить на широкую тарелку.
Приятного аппетита!
Рецепт 1: дрожжевой пирог с вареньем в духовке (с фото)
Чтобы приготовить этот рецепт пирога, используем дрожжевое тесто.
- кефир — 350 мл;
- яйцо — 2 шт. (в тесто) + 1 шт. (для смазывания пирога);
- масло сливочное — 40 г;
- сахар — 100 г;
- сухие дрожжи — 10 г;
- корица — 10 г;
- соль — 1 щепотка;
- мука — 700 г;
- густое варенье или джем (я готовила с виноградным джемом) — 150 г;
- растительное масло для смазывания формы.
В теплый кефир всыпать дрожжи, корицу, соль, 1 столовую ложку сахара.
Добавить 3-4 столовые ложки просеянной муки.
Перемешать всю массу, накрыть полотенцем и поставить в теплое место для активации дрожжей (это займем 15-20 минут). За это время на поверхности опары появится пышная «шапочка».
Пока опара созревает, соединить в отдельной миске 2 куриных яйца, мягкое сливочное масло и оставшийся сахар.
Перемешать вручную или с помощью миксера смесь яиц и масла до однородности.
Когда опара созреет (то есть на поверхности опары появится «шапочка»), добавить её в сладкую яично-масляную массу, перемешать.
Ввести частями просеянную муку, замешивая мягкое, покладистое тесто.
Тесто должно напоминать детский мягкий пластилин и не должно прилипать к рукам.
Тесто поставить в теплое место, чтобы оно увеличилось в объёме раза в 2 (для этого может понадобиться от одного до двух часов).
Форму для выпечки смазать растительным маслом. Тесто разделить на 2 неравные части. Большую часть теста раскатать по диаметру вашей формы и застелить им дно. Толщину теста каждый регулирует под свой вкус: любите больше теста — раскатывайте тесто толщиной в 6-7 мм.
Отступив от края теста 1 см, острым ножом по периметру формы сделать не глубокий надрез (это нужно для образования бортика, чтобы в процессе выпечки растаявшее горячее варенье не стало подтекать).
Варенье (или джем) выбирайте густое.
По всей поверхности, не смазывая отделенный край, нанести толстый слой джема (как на фото), разровнять вилкой.
На столе, присыпанном мукой, отложенную меньшую часть теста раскатать в тонкий пласт толщиной, примерно, 2-3 мм и нарезать на тонкие полоски (можно для нарезки использовать фигурный нож). Нарезанные полоски теста выложить поверх джема в произвольном порядке. По краю теста сформировать бортик. Накрыть пирог салфеткой так, чтобы салфетка не прикасалась к джему, и оставить на расстойку на 15-20 минут.
Одно куриное яйцо взбить до однородности и смазать всю поверхность теста.
Дрожжевой пирог с вареньем выпекать в разогретой духовке 20-25 минут при температуре 180 градусов.
Перед подачей пирог должен полностью остыть.
Нарядный, ароматный дрожжевой пирог с вареньем, испеченный в духовке, своим прекрасным вкусом понравится многим.
Как сделать сухое варенье — советы шеф-поваров
Этот рецепт по отзывам многих людей очень простой, но даже для этого блюда существуют рекомендации от кулинаров, которые помогут в готовке. Если вы хотите сделать в духовке вкусное сухое варенье, придерживайтесь следующих рекомендаций:
- Перед засушиванием можно провести варку для сочных фруктов, ягод. Делать это следует не долго, на слабом огне, чтобы успел в плоды проникнуть сахар, что поможет сохранить форму долькам.
- Лучший способ хранения цукатов зимой – послойно в деревянных ящиках. Сначала кладется бумага, затем само варенье и сахар, затем вновь бумага и повторение слоев.
- В некоторых рецептах сухого варенья из яблок в духовке указывается, что подходят даже переспевшие или «битые» плоды. Велика вероятность, что они превратятся во время приготовления в кашицу. Лучше подходят недозревшие или спелый фрукты, чтобы во время термической обработки они сохранили свою форму.
Как сделать рогалики с изюмом

Ингредиенты:
- Для теста:
- Мука — 500 гр.
- Соль — щепотка
- Дрожжи — 12 гр.
- Сахарный песок — 55 гр.
- Теплая вода — 150 мл.
- Теплое молоко — 100 мл.
- Сливочное масло — 100 гр. для теста + (250 для пласта)
- Яйцо — 1 шт
- Изюм — 100 гр.
Способ приготовления:
1. Вливаем в миску теплую воду, добавляем сахарный песок, перемешиваем, всыпаем дрожжи снова размешаем и оставляем на минут 10, пусть активируются. Они должны начать работать (пениться), если этого не произошло, лучше заменить.
2. Просеиваем муку, к ней всыпаем соль и сахар, хорошо руками перемешиваем. В середине, как всегда делаем углубление и вливаем проснувшиеся дрожжи. Сюда же вольем теплое молоко. И начинаем аккуратно замешивать руками, круговыми движениями.

3. Когда мука соединится с жидкостью, добавляем размягченное сливочное масло. После того, как масло интегрируется с тестом и перестанет липнуть к рукам, выкладываем на столешницу, присыпать дополнительно не нужно и начинаем месить.

4. Формируем из массы плотный прямоугольник, упаковываем его в пищевую пленку и убираем в холодильник на 4 часа, лучше на ночь.
5. Заранее достаем из холодильника масло, чтобы как следует размягчить. Выкладываем этот кусок на пергамент и сначала руками превращаем в лепеху.

6. Сооружаем из пергамента конверт 20*20 и с помощью скалки раскатываем. Аккуратный ровный квадрат у нас должен получиться. Отправляем в холодильник, так же на 4 часа.

7. Ингредиенты охладились, подготовились, заранее достаем и продолжаем. Присыпаем стол мукой и так же излишки теста стряхиваем. Вооружаемся скалкой и начинаем раскатывать. По итогу нам нужен прямоугольник в два раза больше, чем квадрат масла. В процессе можно измерять.

8. Выкладываем на тесто масло и запечатываем его. Теперь от середины в одном направлении раскатываем. Загибаем сверху, примерно треть и снизу 2/3 и немного подкатываем, особенно в месте стыка.

9. Теперь складываем вдвое, немного расплющиваем, упаковываем в пергамент и убираем на час в холодильник. Снова раскатываем в тонкий прямоугольник и загибаем с двух сторон, приплющиваем, и опять же в пергаменте в холодильник на пол часа.

10. Наконец, масса окончательно готова. Выкладываем на столешницу присыпанную мукой и не торопясь делаем раскатку. Толщина 4-5 мм, длина 64 мм, ширина 30 мм. Теперь из получившегося пласта, нарезаем треугольники.

11. Сразу застелем противень пергаментом, включим духовку на 200 градусах. Посыпаем по всей длине заготовки изюм, делаем надрез у основания, беремся за уголки, скручиваем и немного скругляем в виде полумесяца.

12. Хорошо взбиваем яйцо и тщательно смазываем круассаны. Ставим выпекаться при 200 градусах 10 минут, затем убавляем на 190 и еще печем 10 минут.

Даем отдохнуть, но не остужаем полностью. Наливаем чай, кофе и смотреть любимый сериальчик. Приятного аппетита.
Домашние рецепты
Рассмотрим пошагово несколько интересных и несложных рецептов варенья из яблок с черноплодной рябиной на зиму. Такие вкусные, ароматные и очень красивые лакомства, приготовленные в домашних условиях, помогут защитить себя и своих близких от простуды и вирусных инфекций.
Варенье из яблок с черноплодной рябиной «Рубиновые дольки»
Это довольно простой в приготовлении рецепт, с которым справится даже начинающий кулинар, а результат порадует и многоопытных хозяек. Для предлагаемого варенья можно использовать яблоки разных сортов, как твердые, так и сочные.
Выход: 4 баночки емкостью 0,5 л
Ингредиенты:
- яблоки – 1,5 кг;
- сахар – 1 кг;
- черноплодная рябина – 1 стакан;
- вода – 1,5 стакана.
Технология приготовления:
- Яблоки тщательно вымываем, разрезаем, удаляем из них семенную коробочку и нарезаем мякоть тонкими дольками. Кожицу снимать не рекомендуется – она поможет сохранить форму ломтиков.
- Ягоды черноплодки отделяем от плодоножек, вымываем, добавляем к нарезанным яблокам.
- В воду всыпаем сахар, варим сироп на слабом огне, постоянно помешивая, до полного растворения сахара.
- Готовым сиропом заливаем фруктово-ягодную смесь и даем ей настояться 2-3 часа.
- Настоявшуюся заготовку доводим до кипения и варим на слабом огне 10 минут, периодически снимая пенку. Перемешиваем крайне аккуратно, чтобы не повредить ломтики. Затем снимаем с огня и даем полностью остыть. На это потребуется около 5-6 часов, но можно оставить и на всю ночь.
- Остывшее варенье вновь доводим до кипения и провариваем на слабом огне 20-25 минут.
- Горячим разливаем в стерилизованные банки и закатываем.
- Баночки переворачиваем вверх дном, накрываем одеялом или большим толстым полотенцем и оставляем до полного остывания.
Вкусное и полезное варенье с ровными дольками нежно-рубинового цвета станет украшением чайного стола.
«Классическое» варенье из яблок и черноплодной рябины
Предлагаемый рецепт с полным основанием можно назвать целебным десертом
В процессе его приготовления стоит обратить внимание на некоторые нюансы, которые помогут получить желаемые густоту сиропа и степень мягкости ягод без излишнего их переваривания, а также позволят сохранить максимальное количество полезных веществ
Выход: 4-5 баночек по 0,5 л
Ингредиенты:
- яблоки – 0,5 кг;
- сахар – 1,5 кг (делим на две части – 0,5 и 1 кг);
- черноплодная рябина – 1 кг;
- корица палочка/молотая – 1 шт./0,5 ч. л.;
- кислота лимонная – 0,5 ч. л.;
- вода – минимум 0,5 л.
Технология приготовления:
Ягоды черноплодной рябины отделяем от плодоножек, вымываем, складываем в дуршлаг и опускаем в кастрюлю с кипящей водой на 5 минут.
Вынимаем дуршлаг с ягодами из кипятка и помещаем его в емкость с холодной водой для охлаждения
Бланширование и перепад температур помогут сделать жесткую кожицу рябины более мягкой и нежной, не нарушив ее целостность.
Из 500 мл горячей воды, в которой бланшировалась черноплодка, и 500 г сахара варим сироп.
Осторожно, стараясь не повредить ягоды, перекладываем их в кипящий сироп, доводим до кипения и провариваем 3-4 минуты. Затем отставляем кастрюлю на несколько часов, лучше всего будет дать черноплодке настояться всю ночь.
Утром очищаем от кожицы яблоки, удаляем из них семенные коробочки, мякоть нарезаем кубиками.
Ягоды в сиропе доводим до кипения, добавляем оставшийся сахар, аккуратно перемешиваем
Выкладываем подготовленные фрукты, вновь доводим до кипения, опускаем в сироп палочку корицы.
Уменьшаем огонь и варим еще некоторое время до желаемой густоты. Если не передерживать заготовку на огне, то фрукты сохранят больше витаминов, как в случае приготовления традиционной «Пятиминутки». Убирает палочку корицы.
За пару минут до выключения добавляем лимонную кислоту (и корицу, если используется молотая).
Горячее варенье раскладываем в баночки и укупориваем.
Это душистое, слегка терпковатое на вкус варенье будет выглядеть, как горсть рубинов в темном сиропе (см. фото), а благодаря присутствию в нем большого количества витаминов, десерт можно назвать целебным сокровищем.
Детали процесса приготовления с использованием антоновки можно посмотреть в следующем видеорецепте:
Шоколадный пирог с вареньем и творогом
Фото: recipelab.ru
Этот вкусный пирог приводит в восторг взрослых и детей.
Тебе понадобится: 130 г сливочного масла, 3 яйца, щепотка соды, 1 ч.л. какао, 9 ст.л. сахара, 200 г муки, 400 г творога, 150 г варенья, шоколад.
Приготовление: Взбей 1 яйцо с половиной сахара и добавь 100 г размягченного сливочного масла. Туда же добавь муку, соду и какао, замеси однородное тесто и меньшую часть положи в морозилку. Смешай творог с оставшимися яйцами, сахаром и маслом.
Раскатай большую часть теста в форму, сверху выложи варенье, а на него – творожную массу. Затри остатками теста из морозилки и шоколадом. Выпекай пирог 45 минут при 180 градусах.










